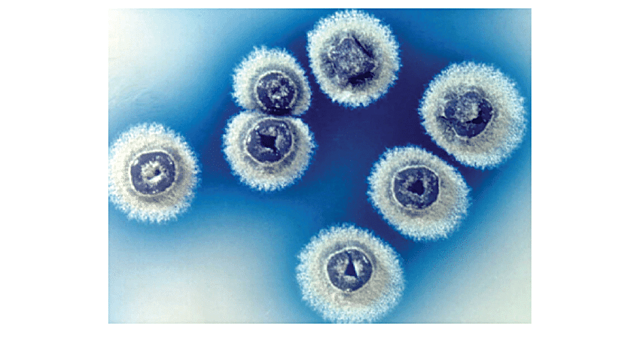
Hopwood y col.

-
Descubrimiento de los elementos transponibles.
Sus innovadores resultados llegaron de la mano de una planta muy utilizada en investigación y en nuestra alimentación diaria: el maíz. Estudiando su genoma, es decir, observando las miles de «letras» que componen su ADN.
Estos genes «saltarines» se les llamó transposones. -
demuestran que el DNA era el material genético de algunos virus.
El material genético esta formado por moléculas de DNA el cual se emplea para guardar la información genética de una forma de vida orgánica. -
Transducción bacteriana.
Él se ciñó al estudio del aparato genético de las bacterias, en concreto al fenómeno que se conoce con el nombre de “transducción” o nuevo sistema de transferencia genética entre bacterias. (Lederberg, J., “Genetic transduction”, American Scientist, 1956; 44: 264-80). -
introduce el concepto de plásmido
Los plásmidos son moléculas de ADN extracromosómico circular o lineal que se replican y transcriben independientes del ADN cromosómico. Están presentes normalmente en bacterias, y en algunas ocasiones. -
Estructura del ADN
El descubrimiento en 1953 de la doble hélice, la estructura retorcida escalera de ácido desoxirribonucleico ADN Watson y Crick publicaron sus hallazgos en un artículo de una página, La más importante de las "nuevas características" del "considerable interés biológico" que describieron era el emparejamiento de las bases en el interior de las dos cadenas principales de ADN: A = T y C = G. -
demuestran la existencia del plásmido F en Escherichia coli.
-
muestran que el RNA era el material genético del virus del mosaico del tabaco.
Tobacco mosaic virus o TMV, es un virus ARN que infecta plantas, especialmente al tabaco y a otros miembros de la familia Solanaceae. La infección produce manchas características en las hojas (de ahí su nombre). -
Regulación de genes por una proteína represora.
Cómo los genes se activan y desactivan para controlar la síntesis de proteínas gracias a los operones, publicado por François Jacob y Jacques Monod hace medio siglo («Genetic regulatory mechanisms in the synthesis of proteins,» J. Mol. Biol. 1961). -
Estructura de la inmunoglobulina.
Determino de la estructura química exacta de un anticuerpo. Usando una enzima llamada papaína, rompió la inmuglobina de la sangre en partes, haciendo más fácil su estudio. También observó como la inmuglobina de la sangre reacciona con la superficie celular. -
Teoría de la selección por clonación
Esta teoría postula que cada antígeno estimulará a aquel linfocito o grupo de linfocitos que poseen en su membrana receptores capaces de reconocer y unirse específicamente a él y que como consecuencia se producirá su proliferación y diferenciación en células con las mismas características de reconocimiento que los linfocitos originales. -
Concepto de operón.
Un operón se define como una unidad genética funcional formada por un grupo complejo de genes capaces de ejercer una regulación de su propia expresión por medio de los sustratos con los que interactúan las proteínas codificadas por sus genes. -
Desarrollo de los radioinmuno-ensayos (RIA).
es un tipo de inmunoensayo o método radioinmunométrico que se basa en la formación específica de los complejos antígeno-anticuerpo (Ag-Ac) lo que le dota de una gran especificidad unido a la sensibilidad de los métodos radiológicos (Isótopos radiactivos). -
Puede definirse como el empleo de organismos vivos para la obtención de un bien o servicio útil para el hombre. Surge en la década de los ’80, y utiliza técnicas, denominadas en su conjunto “ingeniería genética”, para modificar y transferir genes de un organismo a otro.
-
El ARN mensajero y los ribosomas como el sitio de la síntesis de proteínas.
Es un tipo de ácido ribonucleico que tiene una función importante en la síntesis proteica.12 Es aquel que transfiere las moléculas de aminoácidos a los ribosomas, para posteriormente ordenarlos a lo largo de la molécula de ARN mensajero (ARNm); estos aminoácidos se unen por medio de enlaces peptídicos para formar proteínas durante el proceso de síntesis de proteínas -
aísla los tRNA, moléculas que incorporan los aminoácidos activados en las proteínas.
-
Descubrimiento del código genético.
descubren que el codón UUU codificaba para el aminoácido fenilalanina, experimento que sentó las bases para la elucidación del código genético. -
Descubrimiento de bacterias que crecen en géiseres.
descubrio que había bacterias que sobrevivían en manantiales donde la temperatura era de 82ºC: era las primeras bacterias extremadamente termofílicas conocidas. -
Descubrimiento de los retrovirus/transcriptasa reversa.
La transcriptasa inversa tiene importantes aplicaciones en biología molecular, incluyendo transcriptasa inversa-reacción en cadena de la polimerasa y la compilación de las bibliotecas de ADNc -
Aislamiento de Thermus aquaticus, fuente de la Taq polimerasa
Proceso que permitía fabricar un número ilimitado de copias de cualquier gen: la reacción en cadena de la polimerasa (más conocida como PCR, por las siglas en inglés de polymerase chain reaction). -
Especificidad de la acción de las enzimas de restricción
Descubren los enzimas de restricción, herramientas esenciales para el desarrollo de la Ingeniería Genética. -
El avance de los conocimientos sobre la fisiología,
la bioquímica y la genética molecular hizo posible
la manipulación experimental del material genético
de las células hasta el punto de poder «trasplantar» a una
bacteria DNA de otro organismo y recoger las proteínas
codificadas por ese DNA exógeno. -
pone a punto un test bacteriano para detectar mutágenos y carcinógenos: el test de Ames.
Es un ensayo biológico para evaluar el potencial mutagénico de compuestos químicos. Puesto que el cáncer está vinculado a menudo con el daño de el ADN, la prueba también sirve como un ensayo rápido para estimar el potencial cancerígeno de un compuesto, ya que las pruebas estándar para la carcinogenicidad hechas sobre roedores toman años para completarse y son caras de realizar -
Tecnicas de ADN recombinante.
(ADNr) son moléculas de ADN formadas mediante métodos de laboratorio conocidos como recombinación genética (como lo son la clonación molecular) para juntar material genético de diversos medios, creando secuencias de DNA que no se encuentran de otra manera en el genoma. -
Anticuerpos monoclonales.
es un anticuerpo producido por un solo clon de linfocitos B. Los anticuerpos monoclonales (en acrónimo mAB, de la frase en inglés con idéntico significado que en español: monoclonal antibody) son anticuerpos idénticos porque son producidos por un solo tipo de célula del sistema inmune, es decir, todos los clones proceden de una sola célula madre. -
Re-arreglo de los genes de la inmunoglobulina.
fue galardonado por sus trabajos sobre el principio genético de la generación de la diversidad de los anticuerpos, publicado en 1976. -
El descubrimiento del ébola
No se conoce el origen del virus, pero pruebas actuales indican que murciélagos frugívoros (de la familia Pteropodidae) pueden ser huéspedes. La enfermedad por el virus del Ebola, antes llamada fiebre hemorrágica del Ebola, es una enfermedad grave, a menudo fatal, con una tasa de letalidad de hasta 90%, causada por el virus del Ebola, que integra la familia de los filovirus. -
reconocen las archeas como el tercer dominio de los seres vivos.
-
desarrolla el método de los dideoxinucleótidos para la secuenciación del DNA.
-
ponen a punto un método químico para la secuenciación del DNA.
-
La erradicación mundial de la viruela fue certificada, basada en las actividades de verificación intensa en los países, por una Comisión de científicos eminentes en 09 de diciembre de 1979 y posteriormente aprobada por la Asamblea Mundial de la salud el 08 de mayo de 1980 como WHA33.3 de resolución. Las dos primeras frases de la resolución que se lea: "habiendo examinado el desarrollo y resultados del programa global sobre la erradicación de la viruela iniciado por la OMS en 1958 y se intensific
-
Caracterización de priones.
descubre los priones, agentes causantes de la encefalopatía espongiforme bovina y de la enfermedad de Creutzfeldt-Jakob. -
Es una disciplina académica que se encarga del estudio de las células en lo que respecta a las propiedades, estructura, funciones, orgánulos que contienen, su interacción con el ambiente y su ciclo vital.
-
Primer cultivos de hipertarmofilos
Aislamiento del primer
procarionte con Tº óptima > 100ºC -
La insulina ayuda a la glucosa a entrar a las células del cuerpo.Si la glucosa no puede entrar en las células, se acumula en la sangre. Si se deja sin tratamiento, la acumulación de azúcar en la sangre pueden causar complicaciones a largo plazo.
-
Descubrimiento del HIV causa del SIDA.
-
demuestran el papel de Helicobacter pylori en la úlcera de estómago.
Helicobacter pylori como causa de úlceras gástricas
En 1984, se descubrió una bacteria que estaba directamente relacionada con la gastritis, ulcera péptica y cáncer gástrico, hoy conocida mundialmente como Helicobacter pylori. -
utilizó la Taq polimerasa para llevar a cabo la PCR (reacción en cadena de la polimerasa).
-
Ecología microbiana molecular.
Gracias a Norman Pace y su aplicación del metodo molecular al estudio de la ecología microbiana hoy en dia permite saber que la diversidad microbiana es mucho mayor que la basada en los cultivos de laboratorio, ya que se les estudia a mayor profundidad. -
descubren Epulopiscium fishelsoni, la mayor célula procariota.
-
Descubrimiento de arqueas marinas.
-
Secuencia completa de un genoma bacteriano.
-
descubren que Vibrio cholerae tiene dos cromosomas circulares.
-
realizaron la secuenciación del genoma de Streptomyces coelicolor.
Streptomyces coelicolor es un representante del grupo de bacterias filamentosas, viven en el suelo responsable de producir la mayoría de los antibióticos naturales utilizados en la medicina humana y veterinaria -
Producida por el subtipo H5N1 del virus Influenza A que puede transmitirse al hombre.
La gripe aviar es una enfermedad infecciosa de las aves causada por los cepas de tipo A del virus de la gripe. Los virus de la gripe aviar normalmente no infectan a los seres humanos sin embargo se han dado casos de cepas hiperpatogenas que han provocado enfermedades respiratorias graves en el hombre -
Es una bacteria Gram-negativa con forma de bacilo. Vive en aguas estancadas a elevadas temperaturas y su crecimiento se ve favorecido por la presencia de materia orgánica. Requiere oxigeno para respirar y posee un flagelo para desplazarse.
-
Craig Venter. Líder del proyecto fundado de manera privada y paralelo al Proyecto del Genoma Humano, dirigió la Expedición Global Oceánica de Muestras (GOS), circunnavegando el globo y recolectando muestras metagenómicas durante todo el viaje. Todas estas muestras se secuenciaron usando secuenciación de escopeta, con la esperanza que nuevos genomas (y por los tanto nuevos organismos) fueran identificados.
-
se secuencia el genoma del saccharopolyspora erythraea el microorganismo productor del antibiótico eritromicina
-
en México aparece un brote de gripe porcina, posteriormente llamada gripe A H1N1.
en 2009 apareció la cepa 2009 H1N1pdm cuya hemaglutinina era distinta a la de los otros virus H1N1 contemporáneos, y que surgió a causa de una triple recombinación de la neuroaminidasa de virus porcinos. Caracterizacion "in vivo" e "in vitro" de la gripe H1N1 (agosto) -
In vitro
Expresión latina que significa en un medio artificial fuera del organismo, como en un tubo de ensayo en un laboratorio. -
Mycobacterium es el único género de la familia de las bacterias Mycobacteriaceae.
El género incluye bacterias caracterizadas por la propiedad de ramificarse y por la resistencia a los ácidos y alcoholes.
Plan projects on a visual timeline
Map milestones, phases, deadlines, and key events in one place so the sequence is easier to see and share. Timetoast is a timeline maker for work, school, research, and stories.